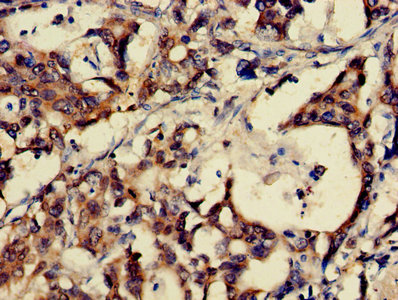

GRP Antibody
-
中文名稱:GRP兔多克隆抗體
-
貨號:CSB-PA009940HA01HU
-
規(guī)格:¥440
-
圖片:
-
其他:
產(chǎn)品詳情
-
產(chǎn)品名稱:Rabbit anti-Homo sapiens (Human) GRP Polyclonal antibody
-
Uniprot No.:
-
基因名:GRP
-
別名:BN antibody; Bombesin antibody; GRP antibody; GRP-10 antibody; GRP_HUMAN antibody; GRP10 antibody; Neuromedin-C antibody; NeuromedinC antibody; Pre progastrin releasing peptide antibody; PreproGRP antibody; ProGRP antibody
-
宿主:Rabbit
-
反應種屬:Human
-
免疫原:Recombinant Human Gastrin-releasing peptide protein (31-98AA)
-
免疫原種屬:Homo sapiens (Human)
-
標記方式:Non-conjugated
本頁面中的產(chǎn)品,GRP Antibody (CSB-PA009940HA01HU),的標記方式是Non-conjugated。對于GRP Antibody,我們還提供其他標記。見下表:
-
克隆類型:Polyclonal
-
抗體亞型:IgG
-
純化方式:>95%, Protein G purified
-
濃度:It differs from different batches. Please contact us to confirm it.
-
保存緩沖液:Preservative: 0.03% Proclin 300
Constituents: 50% Glycerol, 0.01M PBS, PH 7.4 -
產(chǎn)品提供形式:Liquid
-
應用范圍:ELISA, IHC
-
推薦稀釋比:
Application Recommended Dilution IHC 1:20-1:200 -
Protocols:
-
儲存條件:Upon receipt, store at -20°C or -80°C. Avoid repeated freeze.
-
貨期:Basically, we can dispatch the products out in 1-3 working days after receiving your orders. Delivery time maybe differs from different purchasing way or location, please kindly consult your local distributors for specific delivery time.
-
用途:For Research Use Only. Not for use in diagnostic or therapeutic procedures.
相關(guān)產(chǎn)品
靶點詳情
-
功能:Stimulates the release of gastrin and other gastrointestinal hormones. Contributes to the perception of prurient stimuli and to the transmission of itch signals in the spinal cord that promote scratching behavior. Contributes primarily to nonhistaminergic itch sensation. Contributes to long-term fear memory, but not normal spatial memory. Contributes to the regulation of food intake.
-
基因功能參考文獻:
- A panel of three tumor markers CYFRA 21.1, HE4 and ProGRP may play a role for discriminating LC from benign lung disease and subtyping as SCLC. PMID: 29729229
- Pro-GRP is sensitive for SCLC diagnosis. Since high marker levels are related to high disease burden, pro-GRP may have a negative prognostic significance. Follow-up studies are required to define its role in clinical practice in monitoring responses to treatment and early relapses PMID: 28967066
- Altogether, these data show that humanized anti-progastrin antibodies might represent a potential new treatment for K-RAS-mutated colorectal patients, for which there is a crucial unmet medical need PMID: 28600477
- Both TRPV1 and GRP are implied in midbrain physiology of importance to neurological and neuropsychiatric disorders. PMID: 27762319
- GRP/GRP-R signaling activation contributes to castration-resistant prostate cancer progression PMID: 27542219
- progastrin expression may be predictive of aggressive tumour behaviour in patients with colorectal cancer. PMID: 28432443
- Thus the combination of favourable in vitro and in vivo properties renders BA1 as more potential antagonist bombesin-peptide for targeting GRP-receptor positive tumor. These properties are encouraging to carry out further experiments for non-invasive receptor targeting potential diagnostinc and therapeutic agent for tumors. PMID: 28088445
- serum level not a biomarker in small cell lung cancer PMID: 29145241
- pro-gastrin releasing peptide has a role in promoting the cell proliferation and progression in small cell lung cancer PMID: 27639644
- Our results suggest that, similar to what happens in neutrophils, gastrin-releasing peptide is a migratory, rather than a proliferative, stimulus, for non-small cell lung carcinoma cells, indicating a putative role for gastrin-releasing peptide and gastrin-releasing peptide receptor in metastasis PMID: 28351312
- Serum Pro-GRP was promising biomarker for SCLC diagnosis. PMID: 28230031
- High proGRP expression is associated with poor response to chemotherapy in small cell lung cancer. PMID: 26886220
- CEA, NSE, CA125 and pro-GRP could serve as biomarkers for SCLC, and CEA and CYFRA21-1 could serve as biomarkers for NSCLC. Pro-GRP, CA125 and CEA were related to the clinical stages of lung cancer PMID: 26560853
- Data show that serum neuron-specific enolase, cytokeratin 19 fragment 21-1, pro-gastrin-releasing peptide, squamous cell carcinoma antigen, tissue inhibitor of metalloproteinase-1, and human epididymis protein 4 are not associated with brain metastases. PMID: 26730601
- Our results suggest that progastrin inhibits the acquisition of a M2-phenotype in human macrophages. PMID: 24901518
- No association of 16 GRP and 7 GRPR variants were found with agoraphobia with/without panic disorder. PMID: 24912045
- the role of autophagy in the degradation of gastrin-releasing peptide and subsequent inhibition of angiogenesis PMID: 24108003
- High serum proGRP levels are associated with small-cell lung cancer. PMID: 24375395
- The Gastrin-releasing peptide(GRP)triggers the growth of HepG2 cells through blocking the ER stress-mediated pathway. PMID: 23379566
- GRP silencing decreases anchorage-independent growth, inhibits cell migration and neuroblastoma cell-mediated angiogenesis. PMID: 24039782
- GRP-expressing C and A delta fibers that coexpress SP or CGRP makes these neurons pruriceptors. PMID: 23615431
- The levels of GRP were upregulated in cells treated with HGF in a dose-dependent manner. HGF-induced expression of Ets-1 and IL-8 was increased more by GRP treatment. PMID: 23924923
- inhibits the process of autophagy in vascular endothelial cells, thereby increasing endothelial cell proliferation and tubule formation PMID: 23608754
- GRP serum level is higher in patients with pruritus in patients with atopic dermatitis. PMID: 23353988
- Tonic stretch of human myometrium increases contractility and stimulates the expression of a known smooth muscle stimulatory agonist, GRP. GRP receptor antagonists attenuate the effect of stretch. PMID: 22411014
- Data indicate that progastrin-releasing peptide (proGRP) assays with both time-resolved immunofluorometric assay (TR-IFMA) and Advanced Life Science Institute (ALSI) ELISA showed good clinical validity. PMID: 22399443
- Percent changes in serum ProGRP showed better correlation to the sum of the tumor diameters (SOD) and prognostic impact than that of NSE. PMID: 22300752
- Results describe the mRNA expression of CRABP1, RERG, and GRP in pituitary adenomas. PMID: 21270509
- nonamidated peptides derived from the C terminus of pro-GRP are expressed in significant quantities in colorectal cancer cell lines PMID: 22202166
- proGRP is a complementary tumour marker for prognosis and treatment monitoring in patients with neuroendocrine tumour PMID: 21415235
- serum-positive non-small-cell lung cancers may have neuroendocrine differentiation PMID: 21529988
- Progastrin-releasing peptide cab be used as a marker for quality control in clinical sample processing and storage. PMID: 22261454
- Abrogating GRP/GRPR signaling specifically down-regulates HP1(Hsbeta) expression and inhibiting GRPR signaling, or ablating HP1(Hsbeta) expression, increases colon cancer cell invasiveness in vitro. PMID: 21281799
- Gastrin-releasing peptide is elevated in prostate neoplasm patients undergoing androgen deprivation therapy and may be involved in the initiation of hormonal escape prostate neoplasms. PMID: 20945407
- GRP promotes the growth of HepG2 cells through interaction with GRPR co-expressed in tumor cells, and subsequently activates MAPK/ERK1/2 via EGFR-independent mechanisms. PMID: 20596631
- Data indicate that various serum proGRP fragments are promising tools for future investigations on the relationship between fragment distribution and diagnosis and prognosis. PMID: 19907206
- GRP/GRP-R play a transient and non-critical role in intestinal development PMID: 11960700
- mRNA transcripts are expressed in tumor cells of patients with small cell lung cancer PMID: 12474049
- ProGRP is a valuable tumour marker for the detection and monitoring of small cell lung cancer (SCLC) and a good tool for discriminating non-small cell lung cancer (NSCLC) versus SCLC PMID: 12820318
- results show that Pro-GRP may be a potential tumor marker for small cell lung carcinoma PMID: 12820319
- Mitogenic effects of GRP in head and neck squamous cells are mediated by activation of the epidermal growth factor receptor. PMID: 13679857
- GRP is over-expressed in esophageal squamous cell carcinoma, and its over-expression may play a role in such carcinoma development and growth PMID: 14764456
- Measuring serum levels in lung cancer patients may be useful in drug therapy monitoring. PMID: 15638385
- GRP is a new angiogenic peptide and that its inhibition offers an attractive tool to reduce tumor burden. PMID: 15750618
- An increase in GRP binding capacity, as a result of GRP-R overexpression, down-regulates PTEN expression. Inhibition of the tumor suppressor gene PTEN may be an important regulatory mechanism involved in GRP-induced cell proliferation in neuroblastomas. PMID: 15849504
- BN/GRP and substance P are involved together with cytokines in the neuroimmunomodulation that occurs in the arthritic joint. PMID: 15899028
- results show that TACE undergoes phosphorylation that regulates release of amphiregulin upon GRP treatment; a signaling cascade of GRP-Src-PI3-K-PDK1-TACE-amphiregulin-EGFR with multiple points of interaction, translocation & phosphorylation is suggested PMID: 16641105
- First evidence is provided that the calcium-ion/calcineurin/NFAT-linked pathway is involved in bombesin-mediated induction of Cox-2, a gene that promotes colon carcinoma invasiveness. PMID: 16909108
- GRP upregulation of ICAM-1 via FAK promotes tumor cell motility and attachment to the extracellular matrix. PMID: 16920698
- BN/GRP is produced by non-neuronal cells in the synovial tissue in rheumatoid and osteoarthritis PMID: 18289674
顯示更多
收起更多
-
亞細胞定位:Secreted. Cytoplasmic vesicle, secretory vesicle lumen.
-
蛋白家族:Bombesin/neuromedin-B/ranatensin family
-
數(shù)據(jù)庫鏈接:
Most popular with customers
-
-
YWHAB Recombinant Monoclonal Antibody
Applications: ELISA, WB, IHC, IF, FC
Species Reactivity: Human, Mouse, Rat
-
-
-
-
-
-